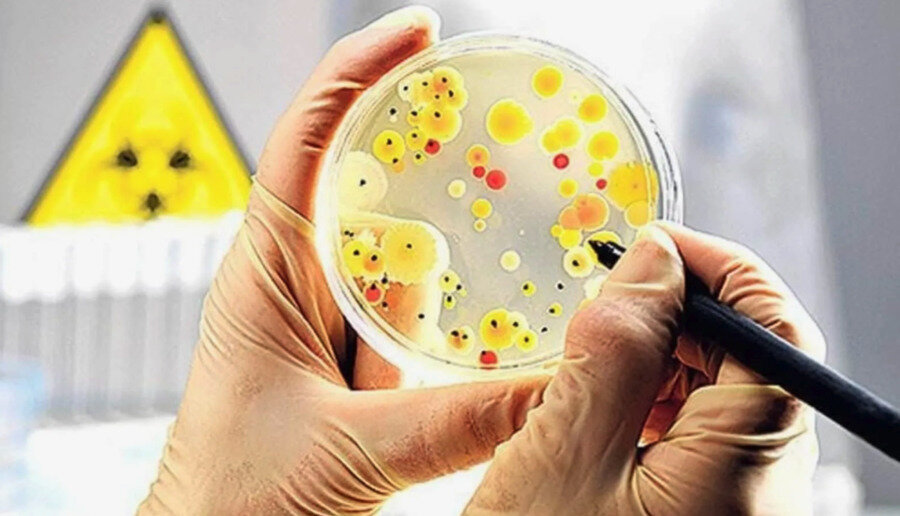
چند عامل بیماریزا در محیط خانه

حتی اگر تشنه نیستید، این ۶ علامت میگوید بدنتان آب میخواهد!
در طول فصل زمستان، با سرد شدن هوا، ما به صورت خودجوش تمایل داریم لایههای بیشتری از لباس را بپوشیم، وسایل گرمایشی را روشن کنیم و نوشیدنیهای گرم بیشتری بنوشیم، در حالی که آب کمتری مینوشیم.
به گزارش پایگاه خبری خبرآنلاین، حتی اگر تشنه نیستید، این ۶ علامت میگوید بدنتان آب میخواهد!
منبع خبر : گروه پزشکی و سلامت خبرآنلاین